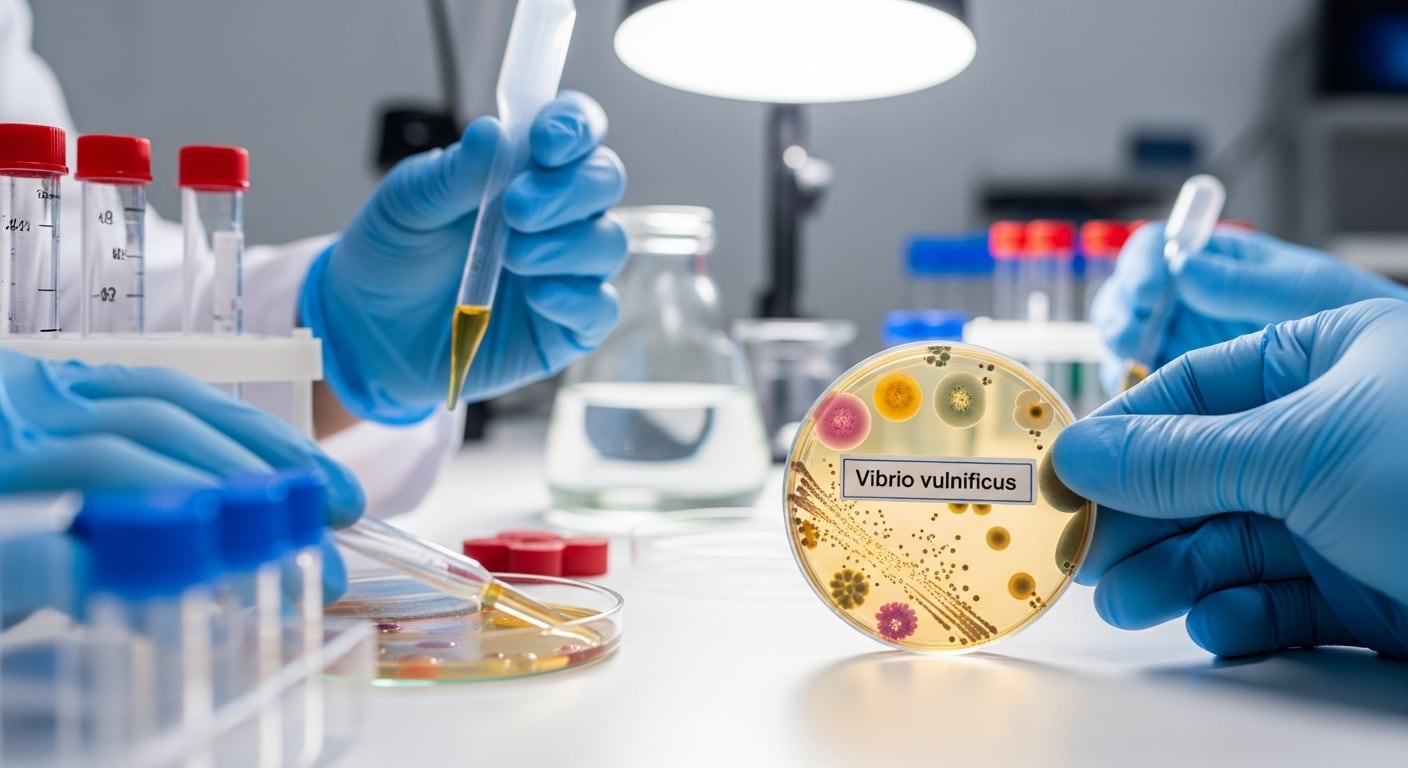
La integración de aceites esenciales en medicina dependerá de que cumplan los mismos criterios de rigurosidad que los medicamentos convencionales (Imagen Ilustrativa Infobae)

En un escenario marcado por el auge de la resistencia bacteriana a los medicamentos, los aceites esenciales de tomillo y romero vuelven a atraer la atención de la comunidad científica internacional.
Del uso milenario al laboratorio

Durante siglos, los aceites esenciales formaron parte de la medicina natural. El enfoque actual se apoya en la investigación científica sobre sus efectos antimicrobianos, explicó la doctora Malwina Brożyna, quien lidera el equipo de investigación en Breslavia.
La investigadora subrayó: “En una era de creciente resistencia microbiana a los antibióticos, se hace cada vez más hincapié en la necesidad de introducir en la terapia productos antimicrobianos a los que los microbios aún no desarrollaron resistencia”. La investigadora lleva casi una década estudiando las propiedades de estos aceites y su potencial terapéutico.
Cada aceite esencial constituye una mezcla compleja de moléculas químicas que actúan de manera simultánea y en diferentes frentes sobre la célula bacteriana, señaló Brożyna. Según el equipo, este efecto combinado puede potenciar la eficacia de los antibióticos y dificultar que las bacterias desarrollen resistencia.
Resultados frente a la bacteria Staphylococcus aureus

Los hallazgos publicados en Frontiers in Microbiology se centraron en los efectos de los aceites de tomillo y romero sobre la bacteria Staphylococcus aureus, responsable de infecciones de la piel y heridas, con cepas especialmente resistentes. Los experimentos se realizaron en condiciones que simulan una herida real.
El aceite de tomillo mostró una mayor eficacia antimicrobiana en comparación con los test estándar de laboratorio, mientras que el de romero presentó un efecto reducido en ese entorno.
“Estas diferencias demuestran cuánto influyen las condiciones en las que se lleva a cabo la investigación en su eficacia”, afirmó Brożyna. El análisis estadístico confirmó que la variabilidad entre cepas bacterianas puede modificar sustancialmente la respuesta al tratamiento con aceites esenciales, lo que pone en duda que estos remedios sean universalmente efectivos. Los autores sostienen que los experimentos deben reproducir fielmente el entorno clínico para una aplicación médica real.
Hacia una gestión responsable
Las conclusiones del estudio impulsaron a los científicos a proponer la “gestión responsable de aceites esenciales”, respaldada por el artículo en Frontiers in Microbiology. Brożyna enfatizó que el entusiasmo por lo natural no puede sustituir el rigor científico. De ahí surge la necesidad de establecer directrices claras para analizar y aplicar estos aceites de manera responsable y reproducible. La gestión responsable implica “un marco reproducible e interdisciplinario para el análisis, la interpretación y la aplicación clínica de los aceites esenciales”.
Innovación metodológica y desafíos
Uno de los avances metodológicos proviene del laboratorio PUMA, dirigido por el doctor Adam Junka, que junto a Brożyna desarrolló guías para evaluar antibióticos, antisépticos y aceites esenciales en entornos similares a infecciones reales. Brożyna explicó: “PUMA es un entorno donde combinamos microbiología, bioingeniería y tecnologías modernas para estudiar procesos biológicos con la máxima fiabilidad”. El equipo prevé incorporar inteligencia artificial para anticipar la eficacia de nuevos compuestos y mejorar la experimentación.
Perspectiva clínica: potencial y cautela

En el plano clínico, los investigadores insisten en la cautela. Los aceites esenciales pueden complementar el tratamiento de infecciones locales, pero requieren formulaciones estables y estandarización rigurosa antes de cualquier uso médico. La química variable según el origen de la planta y las diferencias en las respuestas bacterianas representan desafíos que no se resuelven con ensayos limitados ni experiencias aisladas.
Estándares y validación en medicina
Los autores concluyeron que la integración de los aceites esenciales en la medicina solo será posible si se fundamenta en estándares internacionales y pruebas reproducibles. Advierten que recurrir exclusivamente a la tradición o a pruebas no controladas puede obstaculizar su validación clínica y retrasar nuevos tratamientos. La aplicación de aceites esenciales contra infecciones dependerá de que sean sometidos al mismo nivel de exigencia que los medicamentos convencionales. Solo así podrán tener un espacio legítimo y seguro en la medicina moderna.